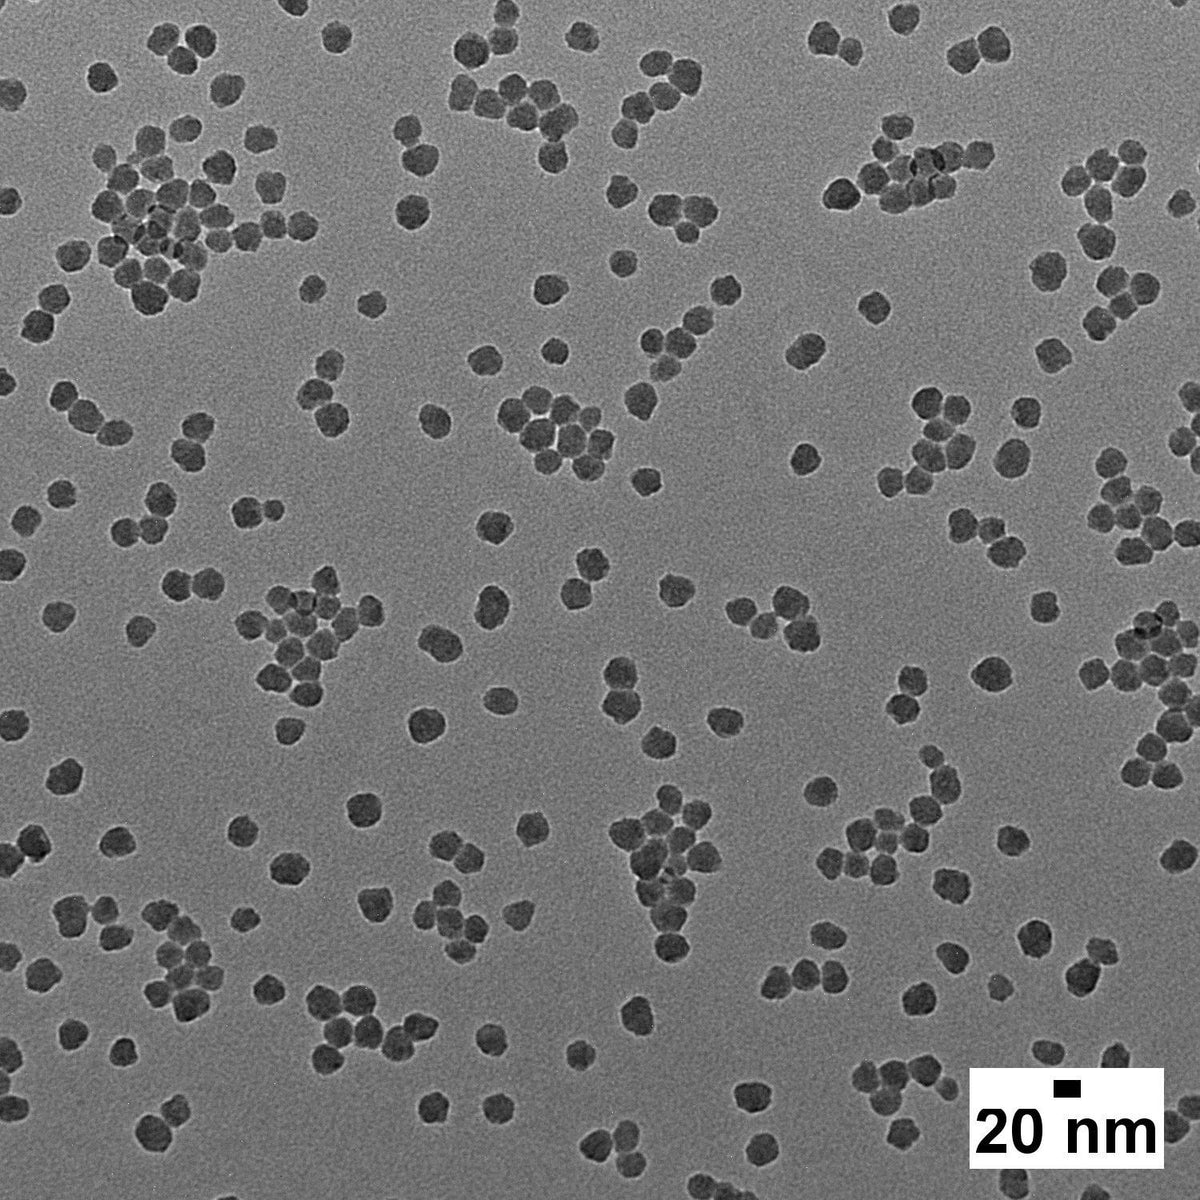
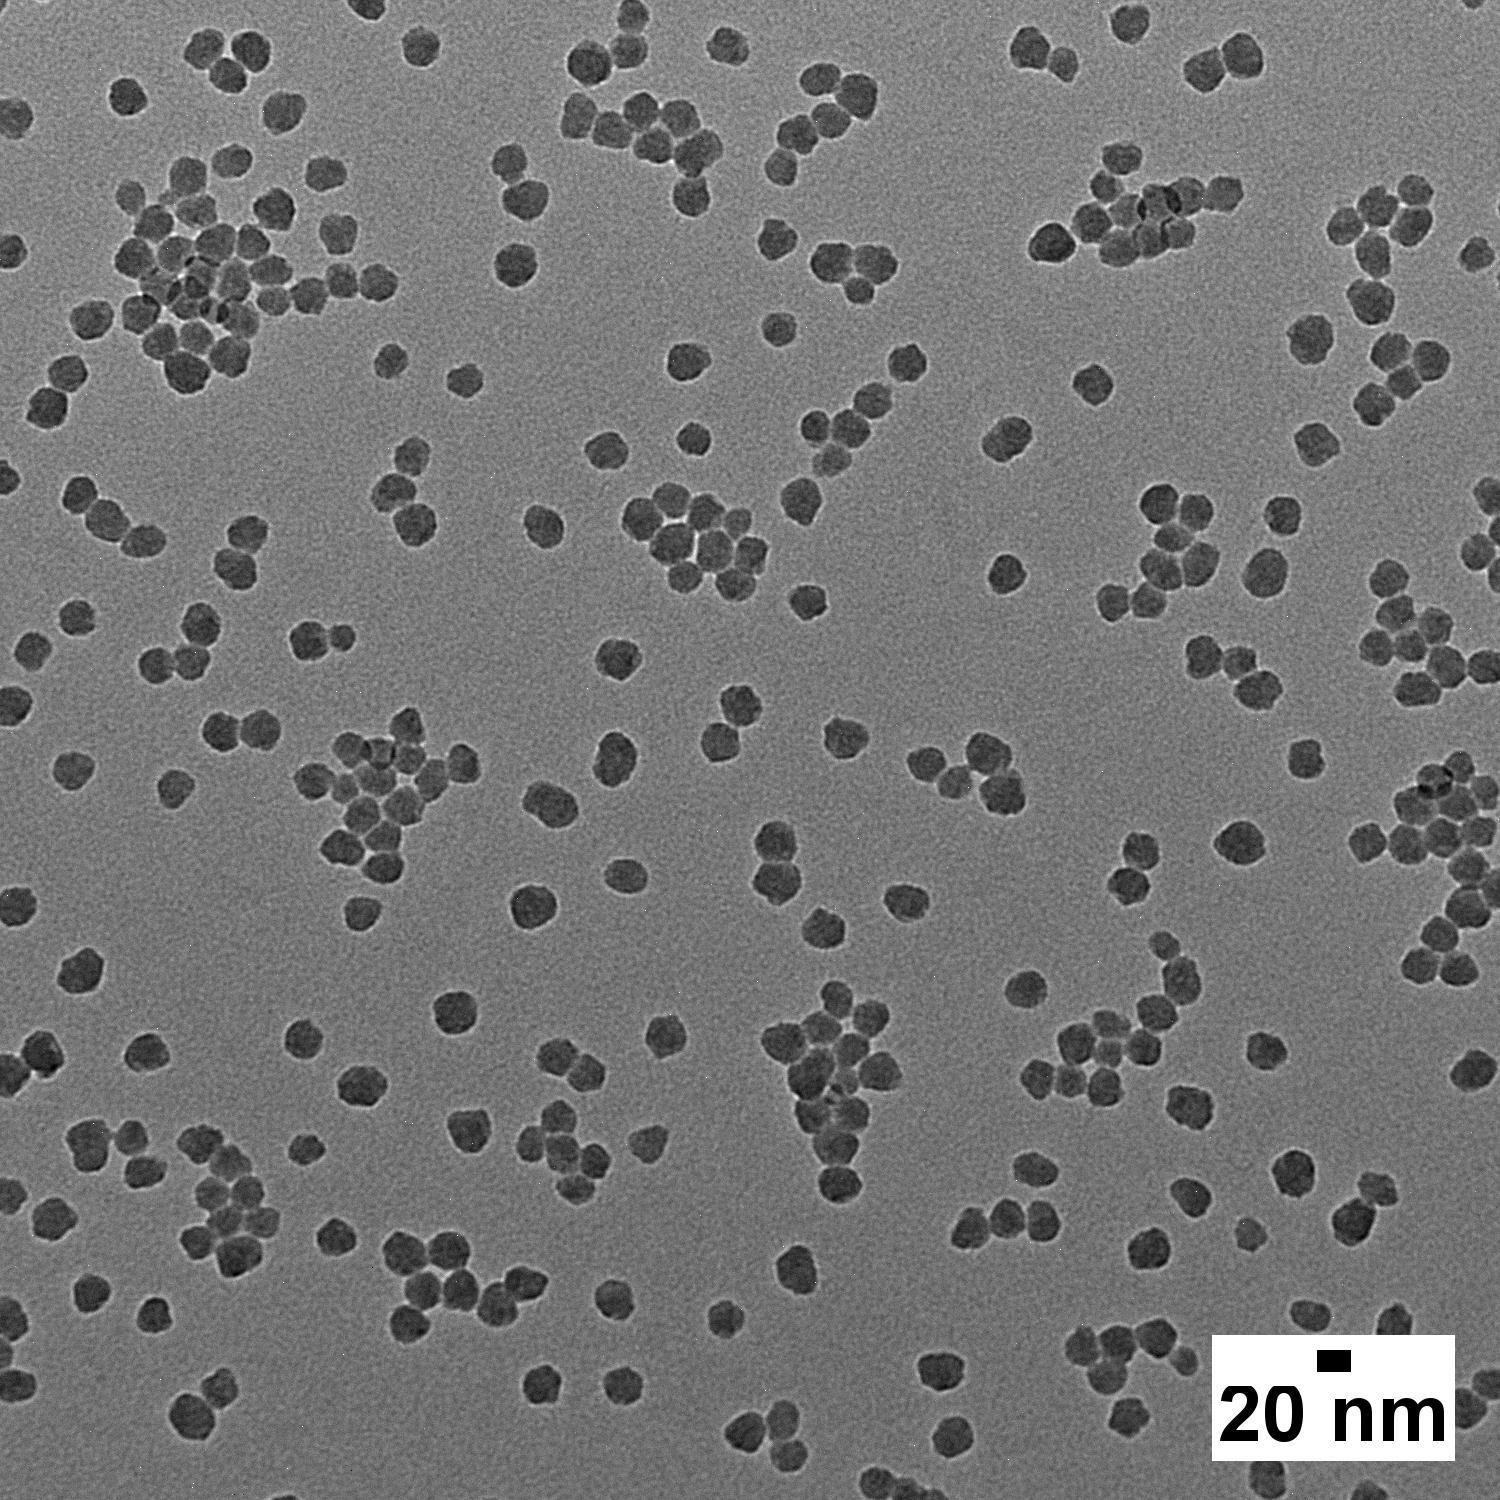
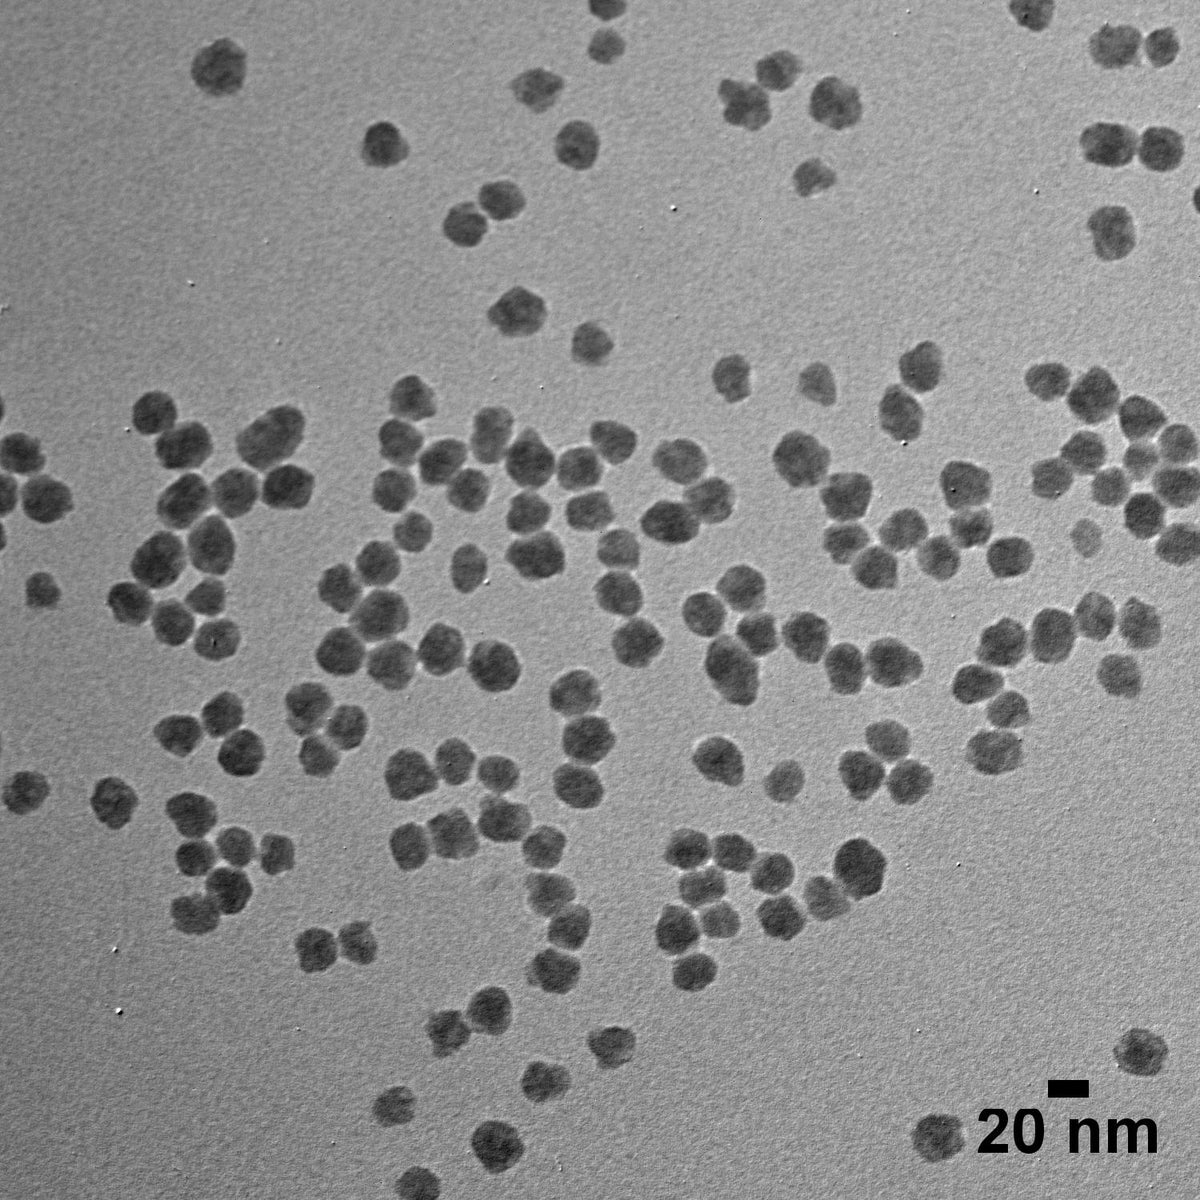

20 nm Silica Nanospheres
Customers outside of the US & Canada: please visit your local distributor’s website to purchase this item using its SKU, or contact us here. Thank you!
20 nm spherical silica nanoparticles are useful in applications such as nanomedicine, targeted drug delivery, UV-scattering, catalysis, and particle size references.
nanoComposix specializes in providing high-purity, monodisperse, and aggregation-free nanomaterials. All our products are supplied with a batch-specific Certificate of Analysis including characterization data such as TEM, DLS, Zeta, and UV-Vis.
Intended for Research Use Only. Not for use in diagnostic procedures. Contact us for custom formulations and ISO 13485/cGMP compliant materials, or bulk supply requirements.
SISN SISN20 SIAN SIAN20| Overview | ||
|---|---|---|
| Surface | Silica | Silica, Aminated |
| Description | Ready-to-use suspension for surface modification or deposition. | Conjugatable surface. Ready-to-use suspension for surface modification or deposition. |
| Solvent | USP Purified Water | Ethanol |
| Surface chemistry | Silanol | Amine |
| Specifications | ||
| Surface | Silica | Silica, Aminated |
| TEM Diameter | 20 ± 4 nm | 20 ± 4 nm |
| CV | ≤ 15% | ≤ 15% |
| Documents | ||
| Surface | Silica | Silica, Aminated |
| Example Certificate of Analysis (CoA) | Download | Download |
| Safety Data Sheet (SDS) | 5 mg/mL (SISN20) | 5 mg/mL (SIAN20) |
| Storage & Handling | Download | Download |
| Expected Ranges | ||
| Surface | Silica | Silica, Aminated |
| Zeta potential | ≤ –25 mV | ≥ 20 mV |
| pH of solution | 7.0–11.0 | N/A |